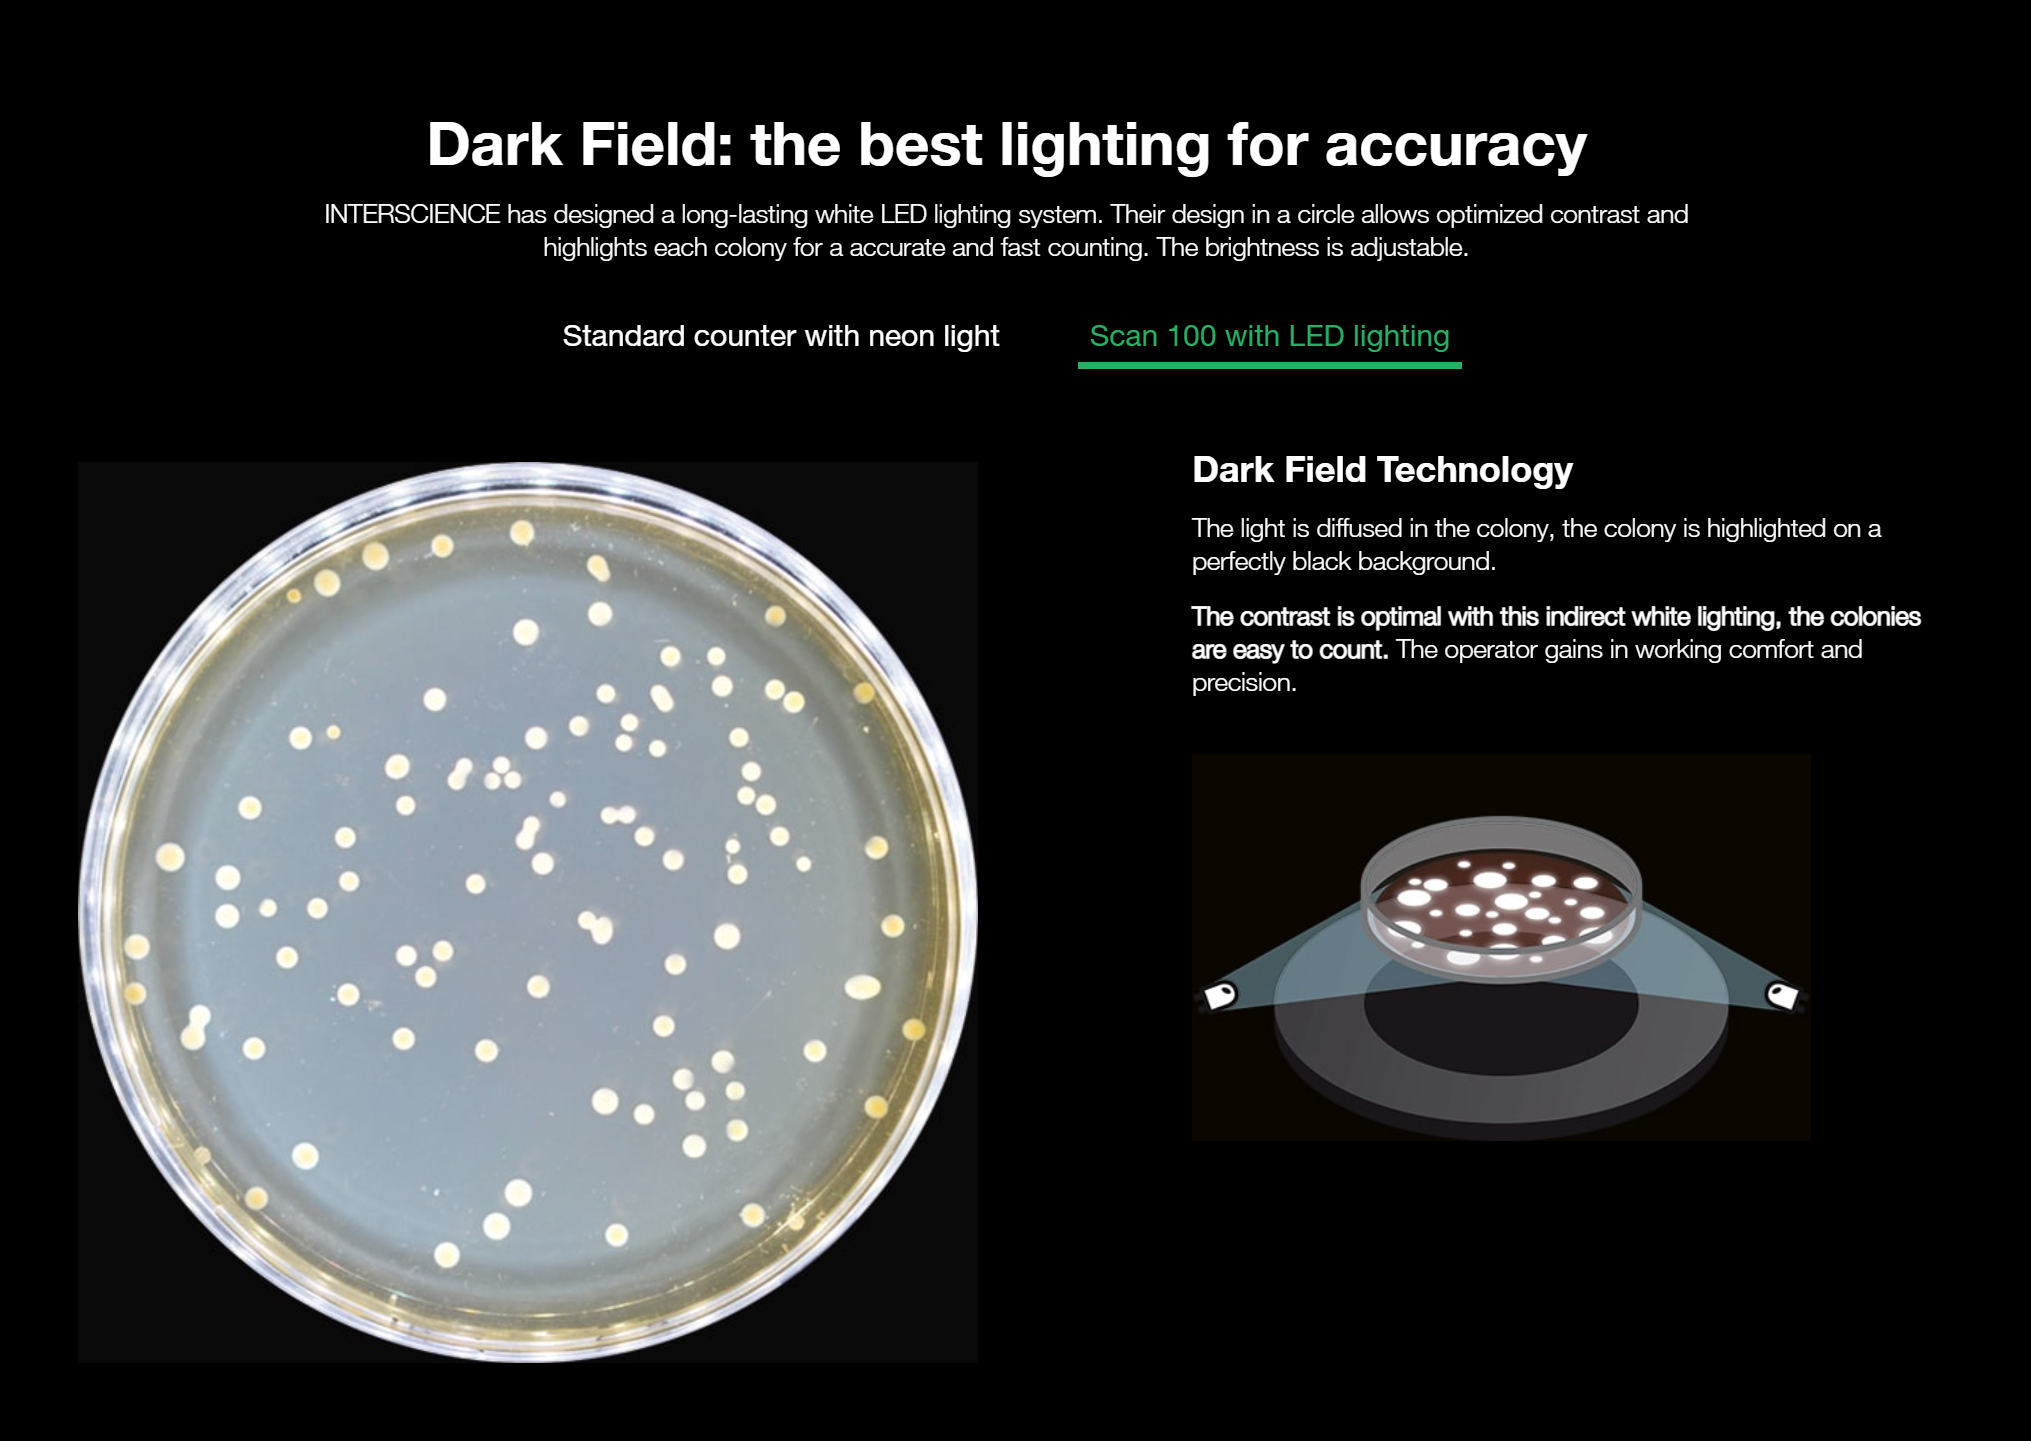

Scan 100
Manual colony counter
the classic
Scan 100 enables the accurate counting of colonies on any type of media. The integrated USB key enables to export the results to guarantee traceability.
- Counting on Petri dishes (Ø 55 to 90 mm), PetrifilmTM, MC‑media PadsTM, Compact DryTM, easyPlateTM, filtration membranes
- White LED lighting with adjustable intensity
- Data export via USB, LIMS and ExcelTM
Compatible with all types of media
Scan 100 is a manual colony counter that is suitable for all types of media: Petri dishes (from Ø 55 to 90 mm), PetrifilmTM, MC‑media PadsTM, Compact DryTM, easyPlateTM, filtration membranes...Counting is done by a simple touch pressure and is then recorded. You can count from 0 to 1999 CFU.

Touch surface with adjustable sensitivity
Counting with Scan 100 is intuitive: count the colonies on your dish, the touch pulse is doubled by a beeping sound. Sensitivity is adjustable via the "sensitivity" wheel.
Great ergonomics
The inclined reading plane and hand rest ensure comfort during the count. An integrated storage space is provided for the counting grids. Scan 100 is compatible with all types of pens or markers.
Traceability
Save time by exporting via USB, LIMS, ExcelTM the data recorded during the count. This will prevent errors in rewriting results.

Applications
The Scan 100 colony counter is used in the food, environmental, pharmaceutical, cosmetics, veterinary and public institutes research.

Scan 100 Brochure Scan100 Technical File